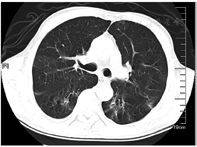

戊二醛是一种易挥发的刺激性醛类有机化合物,属于高效消毒剂,对眼、呼吸道和消化道黏膜及皮肤有强烈的刺激作用,使黏膜蛋白质变性液化坏死。本文对1例口服及吸入高浓度戊二醛中毒患者的救治过程进行分析,探讨高浓度戊二醛中毒的临床表现和转归,为临床治疗提供依据。
版权归中华医学会所有。
未经授权,不得转载、摘编本刊文章,不得使用本刊的版式设计。
除非特别声明,本刊刊出的所有文章不代表中华医学会和本刊编委会的观点。
戊二醛是一种易挥发、有刺激性的醛类有机化合物,是医院和实验室广泛使用的消毒剂和灭菌剂;意外接触过量戊二醛可发生吸入性中毒[1],肠镜检查与治疗后清洗不净,残留的戊二醛也可能诱发结肠炎及化学性腹膜炎[2,3]。戊二醛具有强刺激性,经口摄入中毒事件报道较少,目前临床上对戊二醛中毒的认识相对不足。我们于2020年7月收治了1例患者因口服大量高浓度戊二醛中毒,且在呕吐过程中气道误吸混有戊二醛的消化液致化学性肺炎,现报告如下。
患者男,58岁,因"自服150 ml高浓度戊二醛6 h"于2020年7月5日23:51急诊入院。患者于7月5日17:15与人争吵后自服150 ml 20%浓度戊二醛,就诊于当地医院,未予洗胃,给予催吐、补液后转诊于我院重症医学科。入院时体格检查:体温36.5 ℃,脉搏110次/min,呼吸35次/min,血压113/73 mmHg;意识清楚,精神萎靡,急性面容,面部潮红,口腔黏膜充血、舌肿胀,呼吸急促,呼吸音粗,双下肺闻及少许湿性啰音;心率110次/min,心律齐,各瓣膜区未闻及病理性杂音;腹平软,左上腹轻度压痛。实验室检查:血常规:白细胞计数12.53×109/L,中性粒细胞百分比91.1%;凝血常规:凝血酶原时间13.3 s,部分活化凝血活酶时间29.1 s,纤维蛋白原2.52 g/L,D-二聚体9.6 mg/L;生化检查:白蛋白35 g/L,乳酸脱氢酶306 U/L,磷酸肌酸激酶290 U/L,淀粉酶612 U/L,血清肌钙蛋白I 0.005 ng/ml,葡萄糖8.9 mmol/L;C反应蛋白67 mg/L;粪便隐血试验阳性;动脉血气分析(面罩吸氧5 L/min):pH 7.36,氧分压(PaO2)75 mmHg,二氧化碳分压(PaCO2)31.7 mmHg,碳酸氢根17 mmol/L,乳酸(Lac)4 mmol/L,氧合指数(P/F)182 mmHg。床旁胸片示双肺渗出、胸腔积液可能。患者既往体健,家属否认其有慢性疾病病史。患者入院诊断为急性戊二醛中毒、消化道化学性灼伤、吸入性肺炎。
患者入院后立即予面罩吸氧、置胃管,甘露醇125 ml联合25%硫酸镁20 ml(每8小时1次)导泻;入院后12 h内予纯牛奶2 000 ml胃管内分次注入后,重复负压抽吸胃液;分别于7月6日0:15、12:50行血液灌流2 h,同时予甲强龙60 mg(每12小时1次)静脉滴注减轻肺水肿和渗出以及抗感染(哌拉西林钠/他唑巴坦4.5 g,每8小时1次),异甘草酸镁0.2 g静脉滴注1次/d保肝,泮托拉唑40 mg静脉滴注1次/d抑酸等对症支持治疗。入院当天患者发热,体温37.9 ℃、血氧饱和度下降至85%,予经口气管插管、呼吸机辅助呼吸、镇痛镇静治疗,患者气道内吸出黄白黏液样痰,复测P/F 255 mmHg[呼气末正压(PEEP)5 cmH2O]。入院后第2天予鼻饲肠内营养混悬液(SP)20 ml/h。入院后第4天肠内营养加量至50 ml/h,P/F下降至149 mmHg(PEEP 8 cmH2O);行气管镜检查示气道充血、水肿,部分气道黏膜坏死、剥脱;肺泡灌洗液培养示铜绿假单胞菌,予限制性液体管理。入院后第5天行经皮气管切开术,逐步撤离镇痛镇静药物,患者口唇破溃伴糜烂,予苏打水清洁口腔;行胸部CT检查示两肺多发渗出,考虑吸入性肺炎、双侧胸腔积液、腹腔积液(图1)。入院后第6天甲强龙减量为60 mg 1次/d,并加用低分子肝素4 000 IU预防深静脉血栓形成和肺微小血栓形成。入院后第10天停用甲强龙,后继续抗感染、全肠内营养支持、气管镜吸痰、肺保护性通气、肺复张及对症支持治疗。入院后第11天患者P/F上升至210 mmHg,胸部CT示两肺渗出较前明显吸收(图2)。


两肺多发渗出、双侧胸腔积液


两肺渗出明显吸收
住院期间患者治疗极不配合、烦躁、拒绝交流,症状逐渐加重,入院后第15天心理科会诊加用奥氮平2.5 g夜间鼻饲、草酸艾司西酞普兰片10 mg 1次/d鼻饲,服药2 d后症状好转,同时P/F上升至253 mmHg,气道分泌物减少,逐步间断撤离呼吸机。入院后第17天复查CT示两肺多发炎症,较前吸收,右肺下叶炎性小结节,双侧胸膜增厚(图3)。患者入院后第19天,呼吸机撤离24 h后动脉血气分析:pH 7.48,PaO2 199 mmHg,PaCO2 36.1 mmHg,P/F 485 mmHg,予更换金属气管导管,后患者经口进流质呛咳,喉镜检查咽喉部未见明显异常。入院后第24天拔除金属气管导管。患者病情平稳,办理出院回当地医院治疗。出院诊断:戊二醛中毒、吸入性肺炎、肺部感染。出院后当地医院继续予抗感染、化痰等对症支持治疗。发病1个月后随访,患者未诉不适,已停用奥氮平和草酸艾司西酞普兰片;8月5日复查胸部CT示两肺渗出基本吸收(图4),3个月后随访未出现吞咽困难、呼吸困难等症状,未留有后遗症。

两肺渗出进一步吸收,右肺下叶炎性小结节可能


右肺下叶小结节
戊二醛是一种优良的蛋白质交联剂,其杀灭微生物主要通过两个活泼的醛基[4],具有挥发性,对眼、呼吸道和消化道黏膜及皮肤有强烈的刺激作用,使黏膜蛋白质变性液化坏死,进一步渗透扩散而增加穿透性损伤的风险[5]。2008年Perera等[6]报道了口服戊二醛和新洁尔灭混合物中毒的病例,表现为严重的喉头水肿和代谢性酸中毒,经治疗后痊愈。Thumtecho等[7]收集了5年内244个戊二醛中毒患者,意外暴露占总数的57.0%,患者除上述症状外有部分出现皮疹、全身反应,甚至死亡;其中,并发神经系统症状和急性肾损伤是导致死亡的相关预后因素。局部接触是戊二醛对人体造成损伤的主要途径,因其有特殊的刺激性气味,误服戊二醛者罕见,而口服后气道直接误吸含有戊二醛胃液中毒者目前国内外未见报道。研究显示,口服戊二醛引起消化道黏膜损伤的严重程度与戊二醛浓度、摄入剂量、pH值、清除时间和是否空腹等有关[8]。
戊二醛的常用质量浓度是2%,本例患者口服的戊二醛浓度是20%,临床中毒早期表现为吞咽困难、口腔剧烈疼痛、分泌物增多和呕吐,由于直接误吸含有戊二醛的胃液导致化学性肺炎、气道黏膜剥脱坏死并继发肺部感染。因戊二醛腐蚀性强,传统的胃肠道净化标准化处置尚有争议,故常规治疗仍以质子泵抑制剂、糖皮质激素和抗生素等为基础[9]。杨贤义等[10]报道了5例口服戊二醛中毒患者,其中1例早期进行了洗胃,CT表现空肠损伤,考虑口服戊二醛后胃幽门反射性痉挛,毒物难以排入小肠,洗胃易导致急性胃扩张及胃穿孔,提示此类中毒早期不宜洗胃。本例患者采用纯牛奶反复胃管注入后抽吸胃内容物,可以减少戊二醛经胃肠道吸收并保护胃黏膜。患者在中毒早期大便隐血阳性,但未出现肉眼所见的呕血、便血等情况,考虑为口唇破溃出血所致。
本例患者主要的临床表现是持续低氧合状态(P/F≤150 mmHg),其可能的机制为吸入混入戊二醛的消化液后,一方面直接刺激、腐蚀气道黏膜,引起急性炎症反应,并破坏肺泡表面活性物质,使肺血管壁和肺泡壁通透性增加,导致肺水肿、胸腔积液[11];另一方面可能诱发免疫反应,上调白细胞介素-4,导致肺泡局部和全身IgE水平增加,且与戊二醛的暴露浓度相关[12],本例患者气管镜下亦可见支气管黏膜剥脱、坏死,后继发感染。早期进行机械通气、限制性液体管理、抗感染等治疗,病程10 d氧合指数上升至200 mmHg以上,病程2周氧合指数上升达300 mmHg,最终临床痊愈。
综上所述,口服戊二醛中毒可引起患者消化道黏膜腐蚀及误吸后气道黏膜腐蚀、化学性肺炎、呼吸衰竭,因腐蚀性较强存在洗胃禁忌证,可予纯牛奶反复胃管注入后负压抽吸,尽可能减少毒物的再吸收及二次伤害。另外,患者因情绪异常或者精神障碍口服戊二醛中毒后,对其身心均造成严重的创伤,应加强人文关怀,必要时短时间使用抗精神病药物,使患者配合治疗,尽早康复。
所有作者均声明不存在利益冲突





















